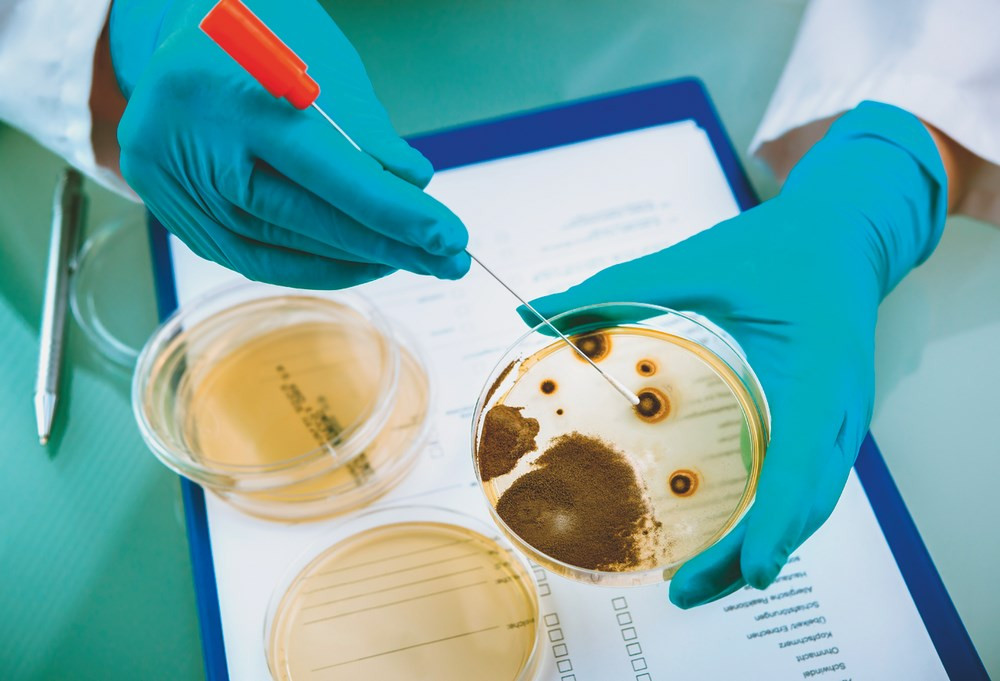

Натуральное – значит безопасное?
На волне массового увлечения ЗОЖ возник настоящий бум всего «натурального». Мы пытаемся чистить зубы углем, питаться ягодами годжи и настаиваем чайный гриб. Но так ли однозначно влияние натуральных продуктов на организм человека?

Воины комбучи
Невероятно, но факт: наибольшую народную любовь снискал чайный гриб или комбуча.
Хотя это вовсе и не гриб, а колония бактерий и дрожжей, выращенных на питательной среде из сахара и чая. В итоге такого «замеса» получается слоистый блинчик, внешне напоминающий шляпку гриба (отсюда и название), который нужно не есть, а пить! Точнее, забродившую жидкость, получившуюся в результате активной деятельности всех участников процесса.
Надо признаться, на вкус этот кисловатый, слегка газированный напиток не так уж плох, особенно если верить в его чудодейственные свойства. Поклонники чайного гриба утверждают, что он может вылечить едва ли не все болезни. Но на деле удалось доказать лишь лёгкий «витаминизирующий» (благодаря присутствию витаминов группы В), антиоксидантный и противомикробный эффект напитка.
Правда, в отношении последнего пункта не до конца понятно, что именно убивает микробы – низкий уровень pH, вызванный образованием уксуса, или ферментативная активность чайных обитателей.
Как бы то ни было, учёные из Корнельского университета показали, что «воины комбучи» способны частично нейтрализовать такие патогены, как Staphylococcus epidermidis, Listeria monocytogenes и Candida parapsilosis. Во избежание недопонимания заранее предупредим: в случае тяжёлого течения инфекции, вызванной одним из этих возбудителей, лечиться чайным грибом очень неблагоразумно! Это всё равно, что ждать облегчения от брусничного морса при пиелонефрите.
Что выросло, то выросло
Не стоит ждать от чайного гриба особых чудес и с точки зрения пробиотической ценности.
В экспертной статье в Food Microbiology недавно разбирался бактериальный состав 5 образцов комбучи, и, вопреки ожидаемому разнообразию, оказалось, что все они на 90% состоят из микроорганизмов одного рода – Gluconacetobacter. Впрочем, можно было бы закрыть глаза на скромный потенциал чайного гриба и просто наслаждаться его приятным вкусом, если бы не возможные риски, которые скрывает в себе этот напиток.
Во-первых, если комбучу готовили в домашних условиях и посуда была плохо простерилизована, туда могли попасть «плохие» бактерии и грибы. И в итоге выросло совсем не то, что предполагалось вырастить. Возможно, вам довелось видеть, как у бабушки на подоконнике чайный «блин» в трёхлитровой банке начинает покрываться чёрной плесенью (Aspergillus niger).
Употреблять напиток с этим непрошеным гостем категорически нельзя: аспергилус может спровоцировать аллергию, бронхиальную астму и даже аспергиллёз (инфекционное заболевание, вызываемое плесневыми грибами рода Aspergillus, который чаще всего поражает органы дыхания, но может прижиться абсолютно в любом органе). Особенно опасны живые патогенные культуры для людей с ослабленной иммунной системой, беременных или кормящих женщин и маленьких детей. Поэтому лучше отказаться от домашней комбучи в пользу покупной пастеризованной.
